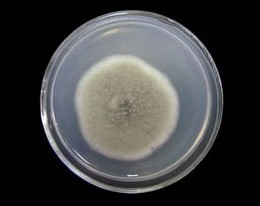
产品封面图

万千商家帮你免费找货
0 人在求购买到急需产品
- 详细信息
- 文献和实验
- 技术资料
- 库存:
34
- 英文名:
Curvularia lunata
- 保质期:
详见说明书
- 供应商:
上海博湖
- 保存条件:
低温冷藏
- 规格:
详见说明书
(1) 新月弯孢品牌菌群:由多种细菌混合组成的相对稳定的细菌群体,具有某些共同性状。如大肠菌群包括大肠杆菌、产气肠细菌及他们之间的过渡类型。
(2) 菌属:菌种的上一级分类,通常性状相近、亲缘关系密切的若干菌种组成一个菌属,如芽孢杆菌属、葡萄球菌属、乳杆菌属等。
(3)是细菌最基本的分类单位,通常指表型特征相似、亲缘关系接近的一类细菌群体,与同属内其他种有着明显差异;当涉及到细菌保存时,菌种是指细菌的种子(用来长期保存)资源。
(4) 菌型:同一菌种的不同细菌,在某些方面存在较小差异的为同一菌型,通常一个菌种内的细菌可以分为多种不同的菌型。
(5) 菌株:由一个独立分离的单细胞系培养而成的纯遗传型群体及其一切后代,一种微生物的每一个不同来源的纯培养物均可称为该菌种的一个菌株。
资源名称 新月弯孢品牌
种属 Curvularia lunata
提供形式 斜面培养物
安全等级 1
模式菌株 no
培养方法 培养基 14
生长条件 25℃
低温存法:
①新月弯孢品牌简单保存法,将琼脂斜面孢子培养物、菌丝悬浮液以及由麸皮、大米、小米等谷物原料制成的孢子培养物置于4℃冰箱保存,保存时间不超过1~2个月,若将谷物原料制备的孢子瓶抽真空并在棉塞上浸蜡,以隔绝外界空气和水汽,保持时间可达3~4个月;②液氮超低温保存法,将生长稳定期的细胞悬浮在10%甘油或其他低冰点液体中,密封于安瓿管内,然后控制冷却速度,使安瓿管温度逐步下降至 -35℃时,即可置于-150~-196℃的液氮罐中保存。大多数微生物如病毒、噬菌体、多种细菌、放线菌、酵母和原虫、特别是一些用冷冻干燥法有困难的微生物,都可用此法长期保存。
脱水存法:
①新月弯孢品牌沙土保存法,能产孢子的细菌、放线菌及霉菌可采用此法保存,即将沙和土以3:2比例混合,经稀酸处理洗净过筛,装入小试管内,装置高度为1cm;灭菌2~3次,烘干后即可将在斜面培养基上生长良好的孢子,用无菌蒸馏水2~2.5ml制成孢子悬液,吸取少许加入沙土管中,经真空抽干,外观呈松散状态,于4℃冰箱保存,保存期可达5~7年。
② 冷冻干燥法,将孢子悬浮液与保护剂(一般用脱脂牛奶或血清)相混合,放在安瓿管内于-20~-30℃的乙醇浴中速冻。然后,在低温下用真空泵抽干,并用或干冰使水汽结冻,熔封安瓿管,于低温下保存。保存期可达5~10年之久。
③ 石蜡油封存法,在斜面菌种培养物上,倒上灭菌后的石蜡油,高出斜面1cm,于4℃冰箱或低温干燥处保存,此法不适用于能利用石蜡油作碳源的微生物,保存期为一年以上。
保藏方法:
1新月弯孢品牌传代培养保藏法
又有斜面培养、穿刺培养、疱肉培养基培养等(后者作保藏厌氧细菌用),培养后于4-6℃冰箱内保存。
2. 液体石蜡覆盖保藏法
是传代培养的变相方法,能够适当延长保藏时间,它是在斜面培养物和穿刺培养物上面覆盖灭菌的液体石蜡,一方面可防止因培养基水分蒸发而引起菌种死亡,另一方面可阻止氧气进入,以减弱代谢作用。
3. 载体保藏法
是将微生物吸附在适当的载体,如土壤、沙子、硅胶、滤纸上,而后进行干燥的保藏法,例如沙土保藏法和滤纸保藏法应用相当广泛。
4. 寄主保藏法
用于目前尚不能在人工培养基上生长的微生物,如病毒、立克次氏体、螺旋体等,它们必须在生活的动物、昆虫、鸡胚内感染并传代,此法相当于一般微生物的传代培养保藏法。病毒等微生物亦可用其他方法如液氮保藏法与冷冻干燥保藏法进行保藏。
5. 冷冻保藏法
可分低温冰箱(-20-30℃,-50-80℃)、干冰酒精快速冻结(约-70℃)和液氮(-196℃)等保藏法。
6. 冷冻干燥保藏法
先使微生物在极低温度(-70℃左右)下快速冷冻,然后在减压下利用升华现象除去水分(真空干燥)。有些方法如滤纸保藏法、液氮保藏法和冷冻干燥保藏法等均需使用保护剂来制备细胞悬液,以防止因冷冻或水分不断升华对细胞的损害。
以下是新月弯孢品牌的相关产品,也是公司正在热销的产品:
锌指蛋白307抗体 Anti-ZNF307 WB IHC-P IHC-F IF 100ul
斑联蛋白抗体 Anti-Zyxin WB IHC-P IHC-F IF 100ul
锌指蛋白474抗体 Anti-ZNF474 WB IHC-P IHC-F IF 100ul
锌指蛋白BED4抗体 Anti-ZBED4 WB IHC-P IHC-F IF 100ul
着丝粒蛋白抗体 Anti-ZW10 peptide WB IHC-P IHC-F IF 100ul
细胞角蛋白15抗体 Anti-CK15 WB IHC-P IHC-F IF 100ul
细胞角蛋白14抗体 Anti-CK14+17+42+10 WB IHC-P IHC-F IF 100ul
神经细胞NB3特定蛋白抗体 Anti-Contactin 6 WB IHC-P IHC-F IF 100ul
促胃泌素受体抗体 Anti-CCKBR WB IHC-P IHC-F IF 100ul
单克隆抗体 Anti-Cocaine WB IHC-P IHC-F IF 100ul
环指蛋白190抗体 Anti-RNF190 WB IHC-P IHC-F IF 100ul
胆碱酯酶抑制剂8抗体 Anti-RIC8A WB IHC-P IHC-F IF 100ul
神经元突触膜胞外分泌调节蛋白1抗体 Anti-ABCA4 WB IHC-P IHC-F IF 100ul
神经元突触膜胞外分泌调节蛋白2抗体 Anti-RIM2 WB IHC-P IHC-F IF 100ul
环指蛋白130抗体 Anti-RNF130 WB IHC-P IHC-F IF 100ul
棒曲霉 深黄被孢霉
紫色直丝链霉菌 改良马丁琼脂培养基70mm
克柔念珠菌冻干粉 桃色欧文氏菌
梨形毛霉 叶柄粘球菌
苏云金芽胞杆菌猝倒亚种 Bacillus thuringiensis subsp. sotto 李克犁头霉或伞枝梨头霉
新月弯孢品牌佛罗里达无孢子侧耳 皮状丝孢酵母 油脂酵母,含油30%
敏捷食酸菌 皮状丝孢酵母 食用及饲料酵母
改良马丁琼脂培养基70mm 玫瑰红表面培养基60mm/25cm2
聚多曲霉(萨氏曲霉) 琼氏不动杆菌
氧化微杆菌 绿色木霉=木素木霉
风险提示:丁香通仅作为第三方平台,为商家信息发布提供平台空间。用户咨询产品时请注意保护个人信息及财产安全,合理判断,谨慎选购商品,商家和用户对交易行为负责。对于医疗器械类产品,请先查证核实企业经营资质和医疗器械产品注册证情况。
文献和实验(2) 孢子体形态:孢子体着生在雌枝顶端,由合子萌发形成,2n。分为基足、蒴柄和孢蒴三部分。基足为一团薄壁细胞,埋于雌枝顶部的组织中,外表看不到。蒴柄细长柱状,上部弧形下弯。孢蒴着生在蒴柄顶端。孢蒴是特殊的孢子囊,结构较复杂。取一孢蒴在实体显微镜下解剖观察下列结构: 蒴帽:孢蒴顶部的帽状物,是颈卵器的一部分(n)、孢蒴成熟后往往脱落。 蒴盖:在蒴帽下面,成熟时黄褐色,圆碟形,其边缘有环带的分化。 蒴齿:用刀片纵切孢蒴,在蒴壶的开口部可看到二轮蒴齿,外齿层长,内齿层短。 蒴壶
生长,叶长卵形,一层细胞厚,具中肋,在茎上螺旋排列。茎的下端具有单列细胞的假根,有分枝。 (2) 孢子体形态:孢子体着生在雌枝顶端,由合子萌发形成,2n。分为基足、蒴柄和孢蒴三部分。基足为一团薄壁细胞,埋于雌枝顶部的组织中,外表看不到。蒴柄细长柱状,上部弧形下弯。孢蒴着生在蒴柄顶端。孢蒴是特殊的孢子囊,结构较复杂。取一孢蒴在 实体显微镜 下解剖观察下列结构: 蒴帽:孢蒴顶部的帽状物,是颈卵器的一部分(n)、孢蒴成熟后往往脱落。
为表皮,内侧为数层细胞的蒴壁。其内为含叶绿体的细胞和很多气室,气室为数层细胞组成的外孢囊,再内为一层孢原组织,孢子即由此产生。蒴盖和蒴壶的连接处为数层细胞构成的环带。蒴壶下面为蒴苔,表面有较多的不能关闭的气孔。孢蒴成熟时,环带常在干燥的条件下自行卷落,蒴盖也脱落,这种方式称为盖裂。蒴齿对大气的干湿度敏感,干燥时,蒴齿尖端向上方向翘起,潮湿时。齿片又微向下弯,这种变化可从齿片边缘带出一些孢子散出。少量孢子伸长,形成长形细胞,特化为弹丝,蒴壁具螺旋状加厚,在受到干、湿条件的影响下,可发生扭曲弹动,有助
技术资料暂无技术资料 索取技术资料